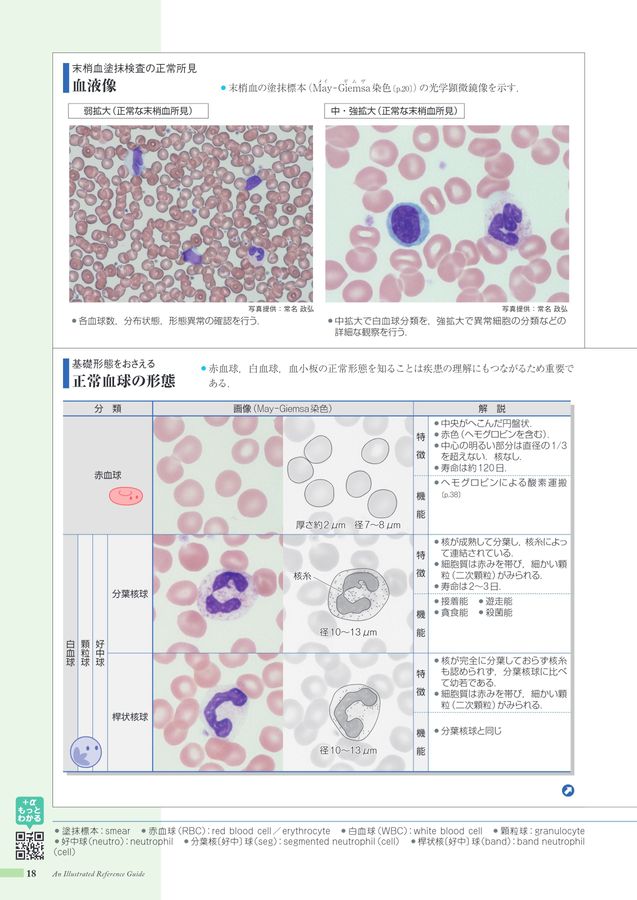
病みえ5-3

マイストア
変更
お店で受け取る
(送料無料)
配送する
納期目安:
2026.03.03 11:47頃のお届け予定です。
決済方法が、クレジット、代金引換の場合に限ります。その他の決済方法の場合はこちらをご確認ください。
※土・日・祝日の注文の場合や在庫状況によって、商品のお届けにお時間をいただく場合がございます。
加藤血液細胞形態学 血球との対話 Amazon.co.jp: 加藤血液細胞形態学: 血球との対話 : 加藤淳: 本の詳細情報
Amazon.co.jp: 加藤血液細胞形態学: 血球との対話 : 加藤淳: 本。医学・獣医学書 近代出版 / エビデンス血液形態学。病みえ5-3。「加藤血液細胞形態学 = Kato's Morphology of Blood Cells : 血球との対話」加藤 淳定価: ¥ 12000美品ですが若干、背の部分が日焼けしています。#加藤淳 #加藤_淳 #本 #自然/医療・薬学・健康自宅保管のためご理解いただける方のみご購入よろしくお願いします。。鍵は“老化で減るKAT7”?― iPS細胞由来血小板産生低下のメカニズムを解明。AKS療法 DVD 4枚組 山内義弘
ベストセラーランキングです
近くの売り場の商品
カスタマーレビュー
オススメ度 4.3点
現在、3933件のレビューが投稿されています。